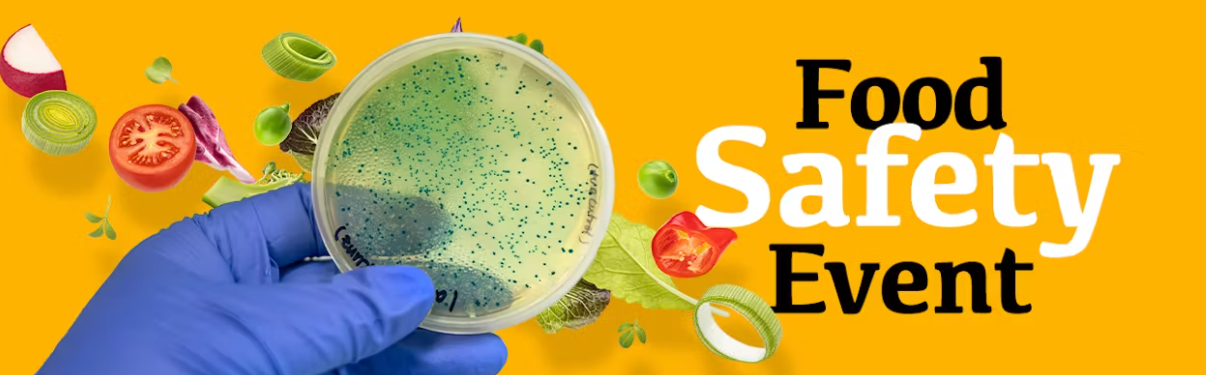
Food Safety Event 2024

Food Safety Event 2024
Op 19 november 2024 vindt Food Safety Event 2024 plaats in de Rijtuigenloods Amersfoort!
Het Food Safety Event 2024 richt zich op het belang van voedselveiligheid en hoe we ons kunnen voorbereiden op onverwachte voedselveiligheidsincidenten. Dit jaar is het thema “Food Safety: Prepare for the Unexpected”.
Je kunt verwachten dat er experts aanwezig zullen zijn die praten over de nieuwste ontwikkelingen en uitdagingen op het gebied van voedselveiligheid. Er zullen ook workshops en interactieve sessies zijn waar je kunt leren hoe je voedselveiligheid in de praktijk kunt verbeteren.
DNV is een partner van VMT.